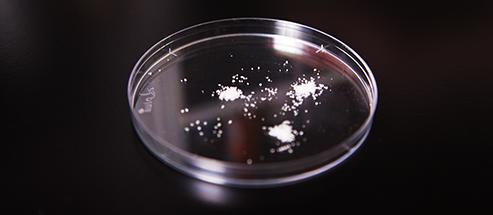
Белый химикат обработки сточных водов порошка ACH-01 алюминиевый Chlorohydrate

Белый химикат обработки сточных водов порошка АКХ-01 алюминиевый Члорохйдрате
Описание:
Ранг Дайлы-чем как антиперспирант алюминиевое Члорохйдрате, неорганическая макромолекулярная смесь; бесцветный или желтый твердый порошок, свое решение показывает бесцветную или свет-желтую прозрачную жидкость; легко растворенный в воде с корозией совершенно.
Спецификации:
|
РАНГ |
Ранг водоочистки (твердая) |
|
Растворимость |
Растворимость в воде |
|
Ал2О3% |
>46 |
|
Кл% |
<18> |
|
Басиситы% |
75-83 |
|
Воднонерастворимые % |
≤0.1 |
|
СО42-ппм |
≤500 |
|
Фе ппм |
≤200 |
|
Кр6+ппм |
≤2.0 |
|
Как ппм |
≤2.0 |
|
Хеавыметал (как Пб) ппм |
≤20.0 |
|
КД ппм |
≤2.0 |
|
Хг ппм |
≤0.1 |
|
ПЭ-АШ 15% водное |
3.5~5.0 |
|
Светлая пропускаемость 15% водное |
|
Область применения:
1. как важный коагулянт флокулянта, широко используемый для обработки сточных водов.
2. специализированный для удаления цвета.
3.косметик в поле химической промышленности дневника
Преимущество:
1. железное содержание может достигнуть <200ppm>
2. лучший результат в обрабатывать сточные воды.
3. меньше дозировки
4. быстрое образование стада с большим размером и быстрым высыпанием
5. свободные образцы для теста.
Пакет и хранение:
1. пакет в 25кг или 50кг в сумку П.Э.
2. Установленный в крутом провентилированном месте
3. полезная жизнь: 2 лет
Информация о компании:
КО. химикатов Исина Клеанватер, Лтд. расположено в провинция Исине, Цзянсу, Китай.
КЛЭАНВАТЭР было установлено в 2003.ве специализирует в обеспечивать химикаты и обслуживает для обработки отработанной воды отбросов производства и городские севаге.ве устанавливали кооперативный механизм с несколькими отечественных университетами и научно-исследовательских институтов на НИОКР новых продуктов. И наша компания исследование, развитие, продукция, торговая операция и обслуживание всестороннего предприятия интегрируя химикатов.
Наш продукт с сильными емкостями обесцвечения и удаления ТРЕСКИ, СОВЕТА ДИРЕКТОРОВ главным образом использован для обработки сточных водов для ткани, печатания, красящ, бумаг-делать, минируя, покрывает краской и так далее. в аддитон, наш агент флокулянта также можно использовать как агент удерживания в продукции папер&пулп. Теперь, около 50% из нашего экспорта продуктов к иностранным рынкам, включая Юго-Восточную Азию, Европу, центральное и Южную Америку и так далее. к тому же, мы устанавливаем хорошее коопратион с клиентами в стране и за рубежом.
Наш принцип «промптнесс, действие, качество и кредит», верил что мы будет удовлетворять каждый вид требования для отечественных и чужих клиентов изделием высокого качества, умеренной ценой, проворной доставкой и непревзойденным обслуживанием